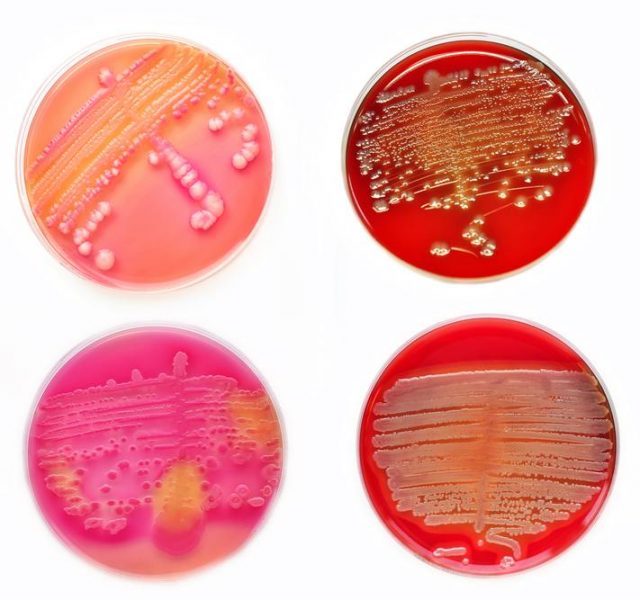
vaginal culture

Las infecciones urinarias son una afección común que afecta a millones de personas cada año. El diagnóstico preciso y el tratamiento oportuno son cruciales para evitar complicaciones graves y prevenir la propagación de la infección.
Las infecciones urinarias son una afección común que afecta a millones de personas cada año. El diagnóstico preciso y el tratamiento oportuno son cruciales para evitar complicaciones graves y prevenir la propagación de la infección.
 El cultivo vaginal es una prueba diagnóstica que se utiliza comúnmente para determinar la causa subyacente de una infección urinaria en las mujeres. La prueba implica tomar una muestra de la secreción vaginal y analizarla en el laboratorio para detectar la presencia de bacterias u otros microorganismos que puedan estar contribuyendo a la infección urinaria.
El cultivo vaginal es una prueba diagnóstica que se utiliza comúnmente para determinar la causa subyacente de una infección urinaria en las mujeres. La prueba implica tomar una muestra de la secreción vaginal y analizarla en el laboratorio para detectar la presencia de bacterias u otros microorganismos que puedan estar contribuyendo a la infección urinaria.
El cultivo vaginal puede ayudar a identificar la presencia de infecciones vaginales, como la vaginosis bacteriana o la candidiasis, que pueden causar infecciones urinarias secundarias. Además, puede identificar la presencia de bacterias que pueden colonizar la vagina y, en algunos casos, pueden ser responsables de infecciones urinarias recurrentes.
Una vez que se identifica la causa subyacente de la infección urinaria, el tratamiento puede dirigirse específicamente a esa infección. Si se identifica una infección vaginal, puede tratarse con cremas o tabletas antifúngicas o antibióticas. Si se identifica una bacteria específica, se puede recetar un antibiótico específico para tratar la infección urinaria.